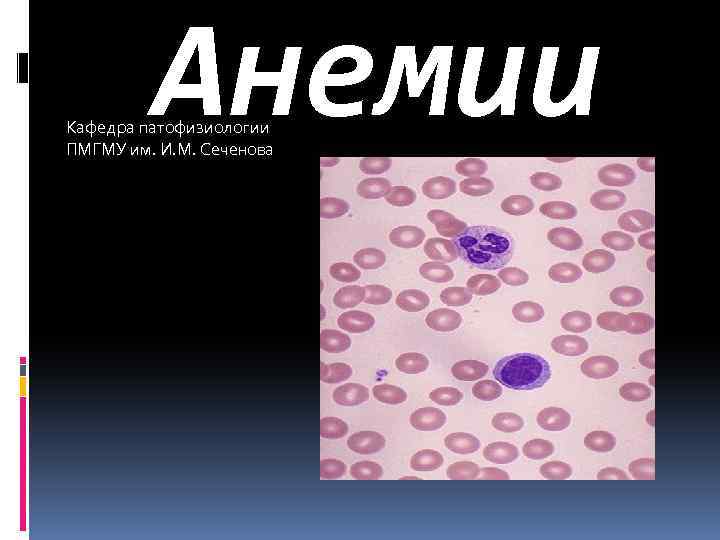
Анемии Кафедра патофизиологии ПМГМУ им. И. М. Сеченова
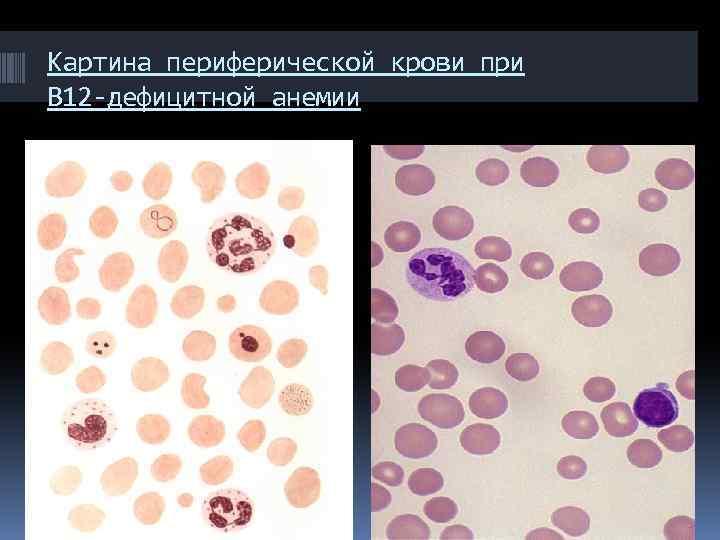
Картина периферической крови при В 12 -дефицитной анемии

Анемии.pptx!.pptx
- Количество слайдов: 59
Анемии Кафедра патофизиологии ПМГМУ им. И. М. Сеченова
Анемии Кафедра патофизиологии ПМГМУ им. И. М. Сеченова
 АНЕМИЯ – это клинико-гематологический синдром, характеризующийся снижением общего количества гемоглобина в единице объема крови (часто, с параллельным снижением количества эритроцитов). Все анемии считаются вторичными. Анемический синдром может быть ведущим в клинике или умеренно выраженным. Кроме общего для всех анемий циркуляторногипоксического синдрома, каждая анемия имеет свои специфические признаки.
АНЕМИЯ – это клинико-гематологический синдром, характеризующийся снижением общего количества гемоглобина в единице объема крови (часто, с параллельным снижением количества эритроцитов). Все анемии считаются вторичными. Анемический синдром может быть ведущим в клинике или умеренно выраженным. Кроме общего для всех анемий циркуляторногипоксического синдрома, каждая анемия имеет свои специфические признаки.
 ВИДЫ АНЕМИИ (1) АНЕМИЯ ПО ПРИЧИНЕ ПЕРВИЧНАЯ ВТОРИЧНАЯ ПО ПАТОГЕНЕЗУ ПОСТГЕМОРРАГИЧЕСКАЯ ГЕМОЛИТИЧЕСКАЯ ДИЗЭРИТРОПОЭТИЧЕСКАЯ ПО ТИПУ КРОВЕТВОРЕНИЯ НОРМОБЛАСТИЧЕСКАЯ МЕГАЛОБЛАСТИЧЕСКАЯ
ВИДЫ АНЕМИИ (1) АНЕМИЯ ПО ПРИЧИНЕ ПЕРВИЧНАЯ ВТОРИЧНАЯ ПО ПАТОГЕНЕЗУ ПОСТГЕМОРРАГИЧЕСКАЯ ГЕМОЛИТИЧЕСКАЯ ДИЗЭРИТРОПОЭТИЧЕСКАЯ ПО ТИПУ КРОВЕТВОРЕНИЯ НОРМОБЛАСТИЧЕСКАЯ МЕГАЛОБЛАСТИЧЕСКАЯ
 ВИДЫ АНЕМИИ (2) АНЕМИЯ ПО РЕГЕНЕРАТОРНОЙ СПОСОБНОСТИ КОСТНОГО МОЗГА РЕГЕНЕРАТОРНАЯ ГИПОРЕГЕНЕРАТОРНАЯ АПЛАСТИЧЕСКАЯ ПО РАЗМЕРУ ЭРИТРОЦИТОВ НОРМОЦИТАРНАЯ МИКРОЦИТАРНАЯ МАКРОЦИТАРНАЯ МЕГАЛОЦИТАРНАЯ ПО ОСТРОТЕ РАЗВИТИЯ ОСТРАЯ ХРОНИЧЕСКАЯ
ВИДЫ АНЕМИИ (2) АНЕМИЯ ПО РЕГЕНЕРАТОРНОЙ СПОСОБНОСТИ КОСТНОГО МОЗГА РЕГЕНЕРАТОРНАЯ ГИПОРЕГЕНЕРАТОРНАЯ АПЛАСТИЧЕСКАЯ ПО РАЗМЕРУ ЭРИТРОЦИТОВ НОРМОЦИТАРНАЯ МИКРОЦИТАРНАЯ МАКРОЦИТАРНАЯ МЕГАЛОЦИТАРНАЯ ПО ОСТРОТЕ РАЗВИТИЯ ОСТРАЯ ХРОНИЧЕСКАЯ
 Мегалобластическая анемия Железодефицитная анемия Талассемия Hb S Сфероцитоз НОРМА Эллиптоцитоз Гемолиз при протезах клапанов сердца АНЕМИИ Акантоцитоз Hb С (признаки анемий различного генеза)
Мегалобластическая анемия Железодефицитная анемия Талассемия Hb S Сфероцитоз НОРМА Эллиптоцитоз Гемолиз при протезах клапанов сердца АНЕМИИ Акантоцитоз Hb С (признаки анемий различного генеза)
 Форма и размер эритроцитов В норме эритроциты имеют диаметр 7, 5 мкм. уменьшение диаметра микроцитоз, увеличение диаметра макроцитоз), при еще больших размерах – мегалоцитоз). без изменений размеров клеток – нормоцитоз, разнородные по диаметру Эр – анизоцитоз. может изменяться форма эритроцитов: сфероцитоз, овалоцитоз, серповидноклеточность. Разная форма пойкилоцитоз.
Форма и размер эритроцитов В норме эритроциты имеют диаметр 7, 5 мкм. уменьшение диаметра микроцитоз, увеличение диаметра макроцитоз), при еще больших размерах – мегалоцитоз). без изменений размеров клеток – нормоцитоз, разнородные по диаметру Эр – анизоцитоз. может изменяться форма эритроцитов: сфероцитоз, овалоцитоз, серповидноклеточность. Разная форма пойкилоцитоз.
 Основные виды пойкилоцитов 1. Овалоциты 2. Сфероциты 3. Дакроциты 4. Эхиноциты 5. Лептоциты 6. Стоматоциты 7. Кодоциты 8. Кератоциты и шизоциты
Основные виды пойкилоцитов 1. Овалоциты 2. Сфероциты 3. Дакроциты 4. Эхиноциты 5. Лептоциты 6. Стоматоциты 7. Кодоциты 8. Кератоциты и шизоциты
 Содержание гемоглобина и регенерация эритроцитов повышенное содержание гемоглобина в эритроцитах гиперхромия, нормальное – нормохромия, сниженное – гипохромия. Часть анемий спровождает анизохромия (полихроматофилия). n Изменяется активность органов эритропоэза (регенерация эритроцитов в крови). Выделяют анемии гипо-, нормои гиперрегенераторные.
Содержание гемоглобина и регенерация эритроцитов повышенное содержание гемоглобина в эритроцитах гиперхромия, нормальное – нормохромия, сниженное – гипохромия. Часть анемий спровождает анизохромия (полихроматофилия). n Изменяется активность органов эритропоэза (регенерация эритроцитов в крови). Выделяют анемии гипо-, нормои гиперрегенераторные.
 Острая постгеморрагическая анемия после массивных кровотечений при язвенной болезни, при разрыве маточной трубы в случае внематочной беременности, разъедании ветви легочной артерии при туберкулезе легких, разрыве аневризмы аорты или ранении ее стенки и отходящих от аорты крупных ветвей.
Острая постгеморрагическая анемия после массивных кровотечений при язвенной болезни, при разрыве маточной трубы в случае внематочной беременности, разъедании ветви легочной артерии при туберкулезе легких, разрыве аневризмы аорты или ранении ее стенки и отходящих от аорты крупных ветвей.
 Хроническая постгеморрагическая анемия при повторных необильных кровопотерях: небольших кровотечениях из распадающейся опухоли ЖКТ, язвы желудка, геморроидальных вен, из полости матки, при геморрагическом синдроме, гемофилии и т. д.
Хроническая постгеморрагическая анемия при повторных необильных кровопотерях: небольших кровотечениях из распадающейся опухоли ЖКТ, язвы желудка, геморроидальных вен, из полости матки, при геморрагическом синдроме, гемофилии и т. д.

 Анемии, связанные с нарушением синтеза ДНК и РНК Витамин В 12 и фолиевая кислота принимают участие в основных этапах обмена пуриновых и пиримидиновых оснований в процессе синтеза ДНК и РНК. В организме содержится 4 мг запаса витамина В 12, которого хватает на 4 года.
Анемии, связанные с нарушением синтеза ДНК и РНК Витамин В 12 и фолиевая кислота принимают участие в основных этапах обмена пуриновых и пиримидиновых оснований в процессе синтеза ДНК и РНК. В организме содержится 4 мг запаса витамина В 12, которого хватает на 4 года.
 В 12 -дефицитная анемия
В 12 -дефицитная анемия
Картина периферической крови при В 12 -дефицитной анемии
Картина периферической крови при В 12 -дефицитной анемии
 В 12 -дефицитная анемия возникает в зрелом возрасте (после 40 лет). Развитие болезни обусловлено выпадением секреции гастромукопротеида в связи с наследственной неполноценностью собственных желез желудка, завершающейся их преждевременной инволюцией. Большое значение имеют аутоиммунные процессы.
В 12 -дефицитная анемия возникает в зрелом возрасте (после 40 лет). Развитие болезни обусловлено выпадением секреции гастромукопротеида в связи с наследственной неполноценностью собственных желез желудка, завершающейся их преждевременной инволюцией. Большое значение имеют аутоиммунные процессы.
 Обмен витамина В 12 (цианкобаламина) Поступление В 12 с пищей (суточная потребность в нем 1 мкг) + Внутренний фактор Кастла в желудке (гастромукопротеин) Всасывается в подвздошной кишке В крови В 12 + транскобаламин-2 Метилкобаламин Фолиевая к-та Тетрагидрофолиевая к-та Синтез ДНК Нормальное кроветворение Портальная вена Печень (депо В 12) 5 -дезоксиаденозилкобаламин Метилмалоновая к-та (токсичная) + пропионовая к-та Янтарная кислота Обмен жирных кислот
Обмен витамина В 12 (цианкобаламина) Поступление В 12 с пищей (суточная потребность в нем 1 мкг) + Внутренний фактор Кастла в желудке (гастромукопротеин) Всасывается в подвздошной кишке В крови В 12 + транскобаламин-2 Метилкобаламин Фолиевая к-та Тетрагидрофолиевая к-та Синтез ДНК Нормальное кроветворение Портальная вена Печень (депо В 12) 5 -дезоксиаденозилкобаламин Метилмалоновая к-та (токсичная) + пропионовая к-та Янтарная кислота Обмен жирных кислот
 Причины дефицита витамина В 12 1. Недостаточное содержание В 12 в пище. 2. Нарушение всасывания: a) нарушение синтеза гастромукопротеина : атрофический гастрит дна желудка; аутоиммунные реакции с продукцией антител к париетальным клеткам желудка и гастромукопротеину; гастрэктомия (после резекции желудка период полувыведения В 12 – 1 год; после гастрэктомии признаки дефицита В 12 возникают через 5 -7 лет); рак желудка; врожденная недостаточность гастромукопротеинов; b) нарушение всасывания В 12 в тонком кишечнике; заболевания тонкого кишечника, сопровождающиеся синдромом мальабсорбции (хронический энтерит, целиакия, спру, болезнь Крона) резекция подвздошной кишки; рак тонкого кишечника; врожденное отсутствие рецепторов к комплексу витамина В 12 + гастромукопротеин в тонком кишечнике; c) конкурентный захват витамина В 12; инвазия широким лентецом; резко выраженный дисбактериоз кишечника. 3. Снижение продукции в печени транскобаламина-2 и нарушение транспорта витамина В 12 в костный мозг (при циррозе печени).
Причины дефицита витамина В 12 1. Недостаточное содержание В 12 в пище. 2. Нарушение всасывания: a) нарушение синтеза гастромукопротеина : атрофический гастрит дна желудка; аутоиммунные реакции с продукцией антител к париетальным клеткам желудка и гастромукопротеину; гастрэктомия (после резекции желудка период полувыведения В 12 – 1 год; после гастрэктомии признаки дефицита В 12 возникают через 5 -7 лет); рак желудка; врожденная недостаточность гастромукопротеинов; b) нарушение всасывания В 12 в тонком кишечнике; заболевания тонкого кишечника, сопровождающиеся синдромом мальабсорбции (хронический энтерит, целиакия, спру, болезнь Крона) резекция подвздошной кишки; рак тонкого кишечника; врожденное отсутствие рецепторов к комплексу витамина В 12 + гастромукопротеин в тонком кишечнике; c) конкурентный захват витамина В 12; инвазия широким лентецом; резко выраженный дисбактериоз кишечника. 3. Снижение продукции в печени транскобаламина-2 и нарушение транспорта витамина В 12 в костный мозг (при циррозе печени).
 Основные патогенетические звенья развития В 12 -дефицитной анемии Нарушение синтеза ДНК в кроветворных клетках, главным образом, эритробластах Нарушение клеточного деления Эмбриональный тип кроветворения (мегалобластный) Мегалобласты редко вызревают до мегалоцитов из-за гемолиза их в костном мозге и не обеспечивают кроветворную функцию (увеличение содержания неконъюгированного билирубина, уробилина, стеркобилина, м. б. повышение сывороточного железа с гемосидерозом внутренних органов) Ядро клетки медленно созревает, в протоплазме повышенное содержание Нв – гиперхромия (тельца Жолли, кольца Кебота), гиперсерментоядерность нейтрофилов
Основные патогенетические звенья развития В 12 -дефицитной анемии Нарушение синтеза ДНК в кроветворных клетках, главным образом, эритробластах Нарушение клеточного деления Эмбриональный тип кроветворения (мегалобластный) Мегалобласты редко вызревают до мегалоцитов из-за гемолиза их в костном мозге и не обеспечивают кроветворную функцию (увеличение содержания неконъюгированного билирубина, уробилина, стеркобилина, м. б. повышение сывороточного железа с гемосидерозом внутренних органов) Ядро клетки медленно созревает, в протоплазме повышенное содержание Нв – гиперхромия (тельца Жолли, кольца Кебота), гиперсерментоядерность нейтрофилов
 Основные дифференциальные критерии В 12 -дефицитной анемии 1. 2. 3. 4. Циркуляторно-гипоксический синдром Нет сидеропенического синдрома Гастроэнтерологический синдром: снижение аппетита, массы тела, глоссит (гладкий красный язык), тяжесть в эпигастрии, неустойчивый стул, ахлоргидрия, м. б. гепатоспленомегалия Неврологический синдром (фуникулярный миелоз): дистрофические процессы в задне-боковых столбах спинного мозга, связанные с накоплением токсичной метилмалоновой кислоты, проявляется: нарушением чувствительности конечностей, изменением походки и координации движений, одеревенением нижних конечностей, нарушением движений пальцев рук, атаксией, нарушением вибрационной чувствительности.
Основные дифференциальные критерии В 12 -дефицитной анемии 1. 2. 3. 4. Циркуляторно-гипоксический синдром Нет сидеропенического синдрома Гастроэнтерологический синдром: снижение аппетита, массы тела, глоссит (гладкий красный язык), тяжесть в эпигастрии, неустойчивый стул, ахлоргидрия, м. б. гепатоспленомегалия Неврологический синдром (фуникулярный миелоз): дистрофические процессы в задне-боковых столбах спинного мозга, связанные с накоплением токсичной метилмалоновой кислоты, проявляется: нарушением чувствительности конечностей, изменением походки и координации движений, одеревенением нижних конечностей, нарушением движений пальцев рук, атаксией, нарушением вибрационной чувствительности.
 Основные дифференциальные критерии В 12 -дефицитной анемии 5. Гематологический синдром : гиперхромная анемия (ЦП выше 1, 1 -1, 3); анизоцитоз (мегалоцитоз), пойкилоцитоз, базофильная зернистость, кольца Кебота, тельца Жолли; трехростковая цитопения; гиперсегментарный нейтрофилез; мегалобластный тип кроветворения (по данным стернальной пункции); снижение В 12 в крови меньше 200 пг/мл;
Основные дифференциальные критерии В 12 -дефицитной анемии 5. Гематологический синдром : гиперхромная анемия (ЦП выше 1, 1 -1, 3); анизоцитоз (мегалоцитоз), пойкилоцитоз, базофильная зернистость, кольца Кебота, тельца Жолли; трехростковая цитопения; гиперсегментарный нейтрофилез; мегалобластный тип кроветворения (по данным стернальной пункции); снижение В 12 в крови меньше 200 пг/мл;
 Фолиево-дефицитная анемия Встречается реже, чем В 12 -дефицитная Запас ФК в организме рассчитан на 2 -3 мес ФК есть во всех продуктах, при нагреве она разрушается Всасывается во всей тощей кишке, м. б. диарея Для всасывания ФК не нужны транспортные белки Врожденные дефекты ФК сочетаются с умственной отсталостью и не корректируются вводом ФК
Фолиево-дефицитная анемия Встречается реже, чем В 12 -дефицитная Запас ФК в организме рассчитан на 2 -3 мес ФК есть во всех продуктах, при нагреве она разрушается Всасывается во всей тощей кишке, м. б. диарея Для всасывания ФК не нужны транспортные белки Врожденные дефекты ФК сочетаются с умственной отсталостью и не корректируются вводом ФК
 Основные дифференциальные критерии фолиево-дефицитной анемии 1. 2. 3. 4. 5. Данные анамнеза : беременность, период новорожденности, хронический алкоголизм, хронический гемолиз, миелопролиферативные заболевания, прием лекарств (антагонисты фолиевой кислоты, противотуберкулезные, противосудорожные препараты). Страдает эритропоэз. Нет фуникулярного миелоза, поражения желудка. Нет ретикулоцитарного криза на прием В 12. В костном мозге красителем окрашиваются мегалобласты только при В 12 дефицитной анемии, а при фолиево-дефицитной анемии – нет. Снижение фолиевой кислоты в крови меньше 3 мг/мл (N – 3 -25 мгмл).
Основные дифференциальные критерии фолиево-дефицитной анемии 1. 2. 3. 4. 5. Данные анамнеза : беременность, период новорожденности, хронический алкоголизм, хронический гемолиз, миелопролиферативные заболевания, прием лекарств (антагонисты фолиевой кислоты, противотуберкулезные, противосудорожные препараты). Страдает эритропоэз. Нет фуникулярного миелоза, поражения желудка. Нет ретикулоцитарного криза на прием В 12. В костном мозге красителем окрашиваются мегалобласты только при В 12 дефицитной анемии, а при фолиево-дефицитной анемии – нет. Снижение фолиевой кислоты в крови меньше 3 мг/мл (N – 3 -25 мгмл).
 Лечение мегалобластных анемий (МГБА) 1. 2. 3. 4. 5. 6. Витамин В 12 (цианокобаламин) – в/м 400 -500 мкг (4 -6 недель). При неврологических расстройствах : В 12 (1000 мкг) + кобаламид (500 мкг) до исчезновения неврологической симтоматики. При необходимости – пожизненное введение В 12 (500 мкг) 1 раз в 2 недели или профилактическое лечение – В 12 (400 мкг) в течение 10 -15 дней 1 -2 раза в год. Переливание эритромассы только по жизненным показаниям (при всех анемиях!): Нв < 50 г/л, Нв < 70 г/л с нарушением гемодинамики, развитие прекомы и комы, срочная подготовка к операции и т. д. Дегельминтизация – выведение лентеца широкого (феносал, мужской папоротник). Фолиевая кислота 5 -15 мг/сут (до 30 мг/сут); профилактическая доза – 1 -5 мг/сут. Критерии эффективности лечения субъективные улучшения в первые дни лечения; ретикулоцитарный криз на 5 -7 день лечения; улучшение показателей крови ко второй неделе лечения, с нормализацией через 3 -4 недели.
Лечение мегалобластных анемий (МГБА) 1. 2. 3. 4. 5. 6. Витамин В 12 (цианокобаламин) – в/м 400 -500 мкг (4 -6 недель). При неврологических расстройствах : В 12 (1000 мкг) + кобаламид (500 мкг) до исчезновения неврологической симтоматики. При необходимости – пожизненное введение В 12 (500 мкг) 1 раз в 2 недели или профилактическое лечение – В 12 (400 мкг) в течение 10 -15 дней 1 -2 раза в год. Переливание эритромассы только по жизненным показаниям (при всех анемиях!): Нв < 50 г/л, Нв < 70 г/л с нарушением гемодинамики, развитие прекомы и комы, срочная подготовка к операции и т. д. Дегельминтизация – выведение лентеца широкого (феносал, мужской папоротник). Фолиевая кислота 5 -15 мг/сут (до 30 мг/сут); профилактическая доза – 1 -5 мг/сут. Критерии эффективности лечения субъективные улучшения в первые дни лечения; ретикулоцитарный криз на 5 -7 день лечения; улучшение показателей крови ко второй неделе лечения, с нормализацией через 3 -4 недели.
 Железодефицитная анемия при недостаточном поступлении железа с пищей, экзогенной недостаточности железа в связи с повышенными запросами организма у беременных и кормящих женщин, при некоторых инфекциях. в основе может лежать резорбционная недостаточность железа, которая встречается при заболеваниях ЖКТ, а также после резекции желудка или кишечника
Железодефицитная анемия при недостаточном поступлении железа с пищей, экзогенной недостаточности железа в связи с повышенными запросами организма у беременных и кормящих женщин, при некоторых инфекциях. в основе может лежать резорбционная недостаточность железа, которая встречается при заболеваниях ЖКТ, а также после резекции желудка или кишечника
 Клинические проявления железодефицитной анемии. Бледность кожных покровов Заеды.
Клинические проявления железодефицитной анемии. Бледность кожных покровов Заеды.
 Железодефицитная анемия
Железодефицитная анемия
 Апластическая анемия (АА) АА – гематологический синдром, обусловленный большим числом эндогенных и экзогенных факторов, качественными и количественными изменениями стволовой клетки и ее микроокружения, кардинальным морфологическим признаком которой является панцитопения в периферической крови и жировая дистрофия костного мозга. П. Эрлих (1888 г) впервые описал АА. Термин «апластическая анемия» введен в 1904 г. Шоффаром. Заболеваемость 4 -5 человек на 1 млн населения в год (в Европе) Возрастные пики заболеваемости 20 и 65 лет
Апластическая анемия (АА) АА – гематологический синдром, обусловленный большим числом эндогенных и экзогенных факторов, качественными и количественными изменениями стволовой клетки и ее микроокружения, кардинальным морфологическим признаком которой является панцитопения в периферической крови и жировая дистрофия костного мозга. П. Эрлих (1888 г) впервые описал АА. Термин «апластическая анемия» введен в 1904 г. Шоффаром. Заболеваемость 4 -5 человек на 1 млн населения в год (в Европе) Возрастные пики заболеваемости 20 и 65 лет
 Апластическая анемия являются следствием угнетения кроветворения, особенно молодых элементов гемопоэза. Причиной развития могут быть как эндогенные, так и экзогенные факторы. Среди эндогенных факторов большое место занимают наследственные. Для эндогенных анемий характерно поражение эритробластического ростка крови с потерей способности костного мозга к регенерации.
Апластическая анемия являются следствием угнетения кроветворения, особенно молодых элементов гемопоэза. Причиной развития могут быть как эндогенные, так и экзогенные факторы. Среди эндогенных факторов большое место занимают наследственные. Для эндогенных анемий характерно поражение эритробластического ростка крови с потерей способности костного мозга к регенерации.
 Апластическая анемия Экзогенными факторами, вызывающими развитие гипопластических анемий, могут выступать лучевая энергия, токсичные вещества, лекарственные препараты (цитостатики, амидопирин, атофан, барбитураты и др. ). При экзогенных анемиях полного подавления гемопоэза не происходит, отмечается лишь угнетение регенераторной способности костного мозга. Присоединяется гемолиз, возникают множественные кровоизлияния в серозных и слизистых оболочках, явления общего гемосидероза, жировая дистрофия миокарда, печени, почек, язвенно-некротические и гнойные процессы, особенно в желудочно-кишечном тракте.
Апластическая анемия Экзогенными факторами, вызывающими развитие гипопластических анемий, могут выступать лучевая энергия, токсичные вещества, лекарственные препараты (цитостатики, амидопирин, атофан, барбитураты и др. ). При экзогенных анемиях полного подавления гемопоэза не происходит, отмечается лишь угнетение регенераторной способности костного мозга. Присоединяется гемолиз, возникают множественные кровоизлияния в серозных и слизистых оболочках, явления общего гемосидероза, жировая дистрофия миокарда, печени, почек, язвенно-некротические и гнойные процессы, особенно в желудочно-кишечном тракте.
 Апластическая анемия
Апластическая анемия
 Этиологические факторы АА лекарства, химические вещества, вирусы, аутоиммунные процессы; в 50% случаев – этиология неизвестна (идиопатические АА). Патогенез АА Функциональная недостаточность костного мозга с угнетением 1, 2 или 3 х ростков (панцитопения). Поражение полипотентной стволовой клетки крови Подавление кроветворения a) Действие иммунных (клеточных, гуморальных) механизмов b) Дефицит факторов, стимулирующих кроветворение c) Железо, В 12, протопорфирин не могут быть использованы кроветворной тканью.
Этиологические факторы АА лекарства, химические вещества, вирусы, аутоиммунные процессы; в 50% случаев – этиология неизвестна (идиопатические АА). Патогенез АА Функциональная недостаточность костного мозга с угнетением 1, 2 или 3 х ростков (панцитопения). Поражение полипотентной стволовой клетки крови Подавление кроветворения a) Действие иммунных (клеточных, гуморальных) механизмов b) Дефицит факторов, стимулирующих кроветворение c) Железо, В 12, протопорфирин не могут быть использованы кроветворной тканью.
 Апластическая анемия может быть 1. 2. Врожденной (с синдромом врожденных аномалий или без него) Приобретенной 1. 2. 3. Острую Подострую Хроническую 1. 2. Иммунная Неиммунная По течению выделяют АА Формы АА Клинические синдромы АА 1. 2. 3. Циркуляторно-гипоксический Септико-некротический Геморрагический
Апластическая анемия может быть 1. 2. Врожденной (с синдромом врожденных аномалий или без него) Приобретенной 1. 2. 3. Острую Подострую Хроническую 1. 2. Иммунная Неиммунная По течению выделяют АА Формы АА Клинические синдромы АА 1. 2. 3. Циркуляторно-гипоксический Септико-некротический Геморрагический
 Данные лабораторных и инструментальных исследований ЦП и содержание железа в эритроцитах в норме (нормохромная А), ретикулоциты снижены (арегенераторная А), повышение сывороточного железа, насыщение трансферрина железом на 100%, эритроциты ↓, НВ ↓ (до 20 -30 г/л), тромбоцитопения (м. б. до 0), лейкопения (м. б. до 200 в мкл), печень, селезенка и лимфоузлы обычно не увеличены, костный мозг (трепанобиопсия подвздошной кости) : аплазия всех ростков, замещение костного мозга жировым. В 80% АА – панцитопения 8 -10% – анемия 7 -8% – анемия и лейкопения, 3 -5% – тромбоцитопения.
Данные лабораторных и инструментальных исследований ЦП и содержание железа в эритроцитах в норме (нормохромная А), ретикулоциты снижены (арегенераторная А), повышение сывороточного железа, насыщение трансферрина железом на 100%, эритроциты ↓, НВ ↓ (до 20 -30 г/л), тромбоцитопения (м. б. до 0), лейкопения (м. б. до 200 в мкл), печень, селезенка и лимфоузлы обычно не увеличены, костный мозг (трепанобиопсия подвздошной кости) : аплазия всех ростков, замещение костного мозга жировым. В 80% АА – панцитопения 8 -10% – анемия 7 -8% – анемия и лейкопения, 3 -5% – тромбоцитопения.
 Тяжелая АА 1. В периферической крови (2 из 3 х ростков угнетены) 2. Миелограмма 3. Трепанобиопсия • • • Гранулоциты 0, 5 -0, 2*109/л Тромбоциты менее 20*109/л Ретикулоциты менее 1% • • Миелокариоциты менее 25 % от нормы Миелокариоциты 25 -50 %, а миелоидные клетки менее 30% • • • При легкой форме – 40% жировой ткани При средней – 80% При тяжелой – абсолютное преобладание жировой ткани (панмиелофтиз) Дифференциальный диагноз АА Дебют острого лейкоза Хронический лимфолейкоз (костно-мозговая форма) Метастазы рака в костный мозг Панцитопения у пожилых людей, как проявление В 12 дефицитной анемии
Тяжелая АА 1. В периферической крови (2 из 3 х ростков угнетены) 2. Миелограмма 3. Трепанобиопсия • • • Гранулоциты 0, 5 -0, 2*109/л Тромбоциты менее 20*109/л Ретикулоциты менее 1% • • Миелокариоциты менее 25 % от нормы Миелокариоциты 25 -50 %, а миелоидные клетки менее 30% • • • При легкой форме – 40% жировой ткани При средней – 80% При тяжелой – абсолютное преобладание жировой ткани (панмиелофтиз) Дифференциальный диагноз АА Дебют острого лейкоза Хронический лимфолейкоз (костно-мозговая форма) Метастазы рака в костный мозг Панцитопения у пожилых людей, как проявление В 12 дефицитной анемии
 ВИДЫ ГЕМОЛИТИЧЕСКИХ АНЕМИЙ ГЕМОЛИТИЧЕСКИЕ АНЕМИИ ПЕРВИЧНЫЕ (НАСЛЕДСТВЕННЫЕ, ВРОЖДЕННЫЕ) ВЫЗВАННЫЕ МЕМБРАНОПАТИЯМИ ВТОРИЧНЫЕ (ПРИОБРЕТЕННЫЕ) ВЫЗВАННЫЕ ГЕМОГЛОБИНОПАТИЯМИ ВЫЗВАННЫЕ ФЕРМЕНТОПАТИЯМИ Белокзависимые: • микросфероцитоз • овалоцитоз • стоматоцитоз • … Липидозависимые: • акантоцитоз гликолиза пентозофосфатного шунта системы глютатиона при талассемии при анемиях с нарушением первичной структуры глобина (Нb. S и др. )
ВИДЫ ГЕМОЛИТИЧЕСКИХ АНЕМИЙ ГЕМОЛИТИЧЕСКИЕ АНЕМИИ ПЕРВИЧНЫЕ (НАСЛЕДСТВЕННЫЕ, ВРОЖДЕННЫЕ) ВЫЗВАННЫЕ МЕМБРАНОПАТИЯМИ ВТОРИЧНЫЕ (ПРИОБРЕТЕННЫЕ) ВЫЗВАННЫЕ ГЕМОГЛОБИНОПАТИЯМИ ВЫЗВАННЫЕ ФЕРМЕНТОПАТИЯМИ Белокзависимые: • микросфероцитоз • овалоцитоз • стоматоцитоз • … Липидозависимые: • акантоцитоз гликолиза пентозофосфатного шунта системы глютатиона при талассемии при анемиях с нарушением первичной структуры глобина (Нb. S и др. )
 Приобретенные гемолитические анемии Изоиммунные Гетероиммунные Аутоиммунные Механическое повреждение эритроцитов Повреждение эритроцитов паразитами, бактериями Укусы змей и пауков Гипофосфатемия Болезнь Маркиафавы-Микели
Приобретенные гемолитические анемии Изоиммунные Гетероиммунные Аутоиммунные Механическое повреждение эритроцитов Повреждение эритроцитов паразитами, бактериями Укусы змей и пауков Гипофосфатемия Болезнь Маркиафавы-Микели
 Причины внутрисосудистого гемолиза 1) механическая травма эритроцитов 2) воздействие экзогенных токсинов 3) фиксация на поверхности эритроцита комплемента
Причины внутрисосудистого гемолиза 1) механическая травма эритроцитов 2) воздействие экзогенных токсинов 3) фиксация на поверхности эритроцита комплемента
 Причины внесосудистого гемолиза Внесосудистый или внутриклеточный гемолиз возникает путем захвата эритроцитов макрофагами селезенки и печени в следствии: 1) фиксации иммуноглобулинов на поверхности эритроцитов и образования эритроцитарного секвестра 2) ограничения возможности деформирования эритроцитов, что затрудняет их прохождение по фильтрационному руслу селезенки
Причины внесосудистого гемолиза Внесосудистый или внутриклеточный гемолиз возникает путем захвата эритроцитов макрофагами селезенки и печени в следствии: 1) фиксации иммуноглобулинов на поверхности эритроцитов и образования эритроцитарного секвестра 2) ограничения возможности деформирования эритроцитов, что затрудняет их прохождение по фильтрационному руслу селезенки
 Общие признаки гемолиза эритроцитов Ретикулоцитоз в периферической крови Эритроидная гиперплазия костного мозга Увеличение непрямого билирубина сыворотки Снижение уровня гаптоглобина сыворотки Укорочение жизни эритроцитов ( определяется при помощи метки эритроцитов Cr 51 ) Для внутрисосудистого гемолиза характерны наличие свободного гемоглобина в плазме, гемоглобинурия и гемосидеринурия Для внутриклеточного гемолиза характерно увеличение селезенки
Общие признаки гемолиза эритроцитов Ретикулоцитоз в периферической крови Эритроидная гиперплазия костного мозга Увеличение непрямого билирубина сыворотки Снижение уровня гаптоглобина сыворотки Укорочение жизни эритроцитов ( определяется при помощи метки эритроцитов Cr 51 ) Для внутрисосудистого гемолиза характерны наличие свободного гемоглобина в плазме, гемоглобинурия и гемосидеринурия Для внутриклеточного гемолиза характерно увеличение селезенки
 Гемолитические анемии связанные с нарушением мембраны эритроцитов Наследственный микросфероцитоз ( болезнь Минковского - Шоффара) Наследственный эллиптоцитоз ( овалоцитоз ) Наследственный стоматоцитоз Абеталипопротеинемия (акантоцитоз, шпороклеточная анемия ) Отсутствие резус - антигенов
Гемолитические анемии связанные с нарушением мембраны эритроцитов Наследственный микросфероцитоз ( болезнь Минковского - Шоффара) Наследственный эллиптоцитоз ( овалоцитоз ) Наследственный стоматоцитоз Абеталипопротеинемия (акантоцитоз, шпороклеточная анемия ) Отсутствие резус - антигенов
 Наследственный микросфероцитоз ( болезнь Минковского - Шафара ) Патогенез Отсутствует один из структурных белков мембраны эритроцита (кальцийзависимая аденозинтрифосфатаза, спектрин) Повышается проницаемость мембраны эритроцитов к ионам натрия Повышенное накопление воды в эритроците Нарушается способность эритроцитов деформироваться в узких участках кровотока Разрушение эритроцитов всинусах селезенки
Наследственный микросфероцитоз ( болезнь Минковского - Шафара ) Патогенез Отсутствует один из структурных белков мембраны эритроцита (кальцийзависимая аденозинтрифосфатаза, спектрин) Повышается проницаемость мембраны эритроцитов к ионам натрия Повышенное накопление воды в эритроците Нарушается способность эритроцитов деформироваться в узких участках кровотока Разрушение эритроцитов всинусах селезенки
 Клинические проявления болезни Минковского - Шафара Гемолитическая анемия с признаками внутриклеточного гемолиза Желтуха за счет увеличения непрямого билирубина Спленомегалия Склонность к образованию камней желчного пузыря с детского возраста Деформация скелета за счет нормобластной гиперплазии костного мозга, что приводит к возникновению башенного, квадратного черепа, высокого неба, микрофтальмии, изменению расположения зубов Гемолитические кризы на фоне даже незначительных инфекции Образование на коже голеней язв
Клинические проявления болезни Минковского - Шафара Гемолитическая анемия с признаками внутриклеточного гемолиза Желтуха за счет увеличения непрямого билирубина Спленомегалия Склонность к образованию камней желчного пузыря с детского возраста Деформация скелета за счет нормобластной гиперплазии костного мозга, что приводит к возникновению башенного, квадратного черепа, высокого неба, микрофтальмии, изменению расположения зубов Гемолитические кризы на фоне даже незначительных инфекции Образование на коже голеней язв
 Лабораторные признаки болезни Минковского - Шафара Морфологические изменения эритроцитов: появляются шарообразные эритроциты уменьшенного диаметра ( микросфероциты ). Они могут составлять основную популяцию эритроцитов или составлять небольшой процент. От их количества зависит тяжесть заболевания. Отсутствует центральное просветление в эритроцитах Cредний объем эритроцита в норме или несколько уменьшен ( меньше 75 fl) Определение осмотической резистентности Понижение осмотической резистентности эритроцитов до 0. 7 - 0. 65% Na. Cl ( норма 0. 46 - 0. 30% Na. Cl) Спонтанный лизис 30 - 40% эритроцитов после двухсуточной инкубации (норма 0. 4 - 4. 5 %)
Лабораторные признаки болезни Минковского - Шафара Морфологические изменения эритроцитов: появляются шарообразные эритроциты уменьшенного диаметра ( микросфероциты ). Они могут составлять основную популяцию эритроцитов или составлять небольшой процент. От их количества зависит тяжесть заболевания. Отсутствует центральное просветление в эритроцитах Cредний объем эритроцита в норме или несколько уменьшен ( меньше 75 fl) Определение осмотической резистентности Понижение осмотической резистентности эритроцитов до 0. 7 - 0. 65% Na. Cl ( норма 0. 46 - 0. 30% Na. Cl) Спонтанный лизис 30 - 40% эритроцитов после двухсуточной инкубации (норма 0. 4 - 4. 5 %)
 Наследственный эллиптоцитоз (овалоцитоз) Патогенез Отсутствие в мембране эритроцита белка 4. 1, играющего важную роль в стабилизации взаимосвязи спектрина и актина в цитоскелете Нарушение способности эритроцитов деформироваться при прохождении узких частей кровотока Внутриклеточный гемолиз
Наследственный эллиптоцитоз (овалоцитоз) Патогенез Отсутствие в мембране эритроцита белка 4. 1, играющего важную роль в стабилизации взаимосвязи спектрина и актина в цитоскелете Нарушение способности эритроцитов деформироваться при прохождении узких частей кровотока Внутриклеточный гемолиз
 Клинические проявления овалоцитоза Гемолитическая анемия, обычно легкая Увеличение овалоцитов до 25 - 75% ( норма до 10% ) Признаки внутриклеточного гемолиза
Клинические проявления овалоцитоза Гемолитическая анемия, обычно легкая Увеличение овалоцитов до 25 - 75% ( норма до 10% ) Признаки внутриклеточного гемолиза
 Наследственный стоматоцитоз Патогенез В основе два дефекта мембраны эритроцитов: 1. увеличение проницаемости для ионов натрия и калия 2. увеличение количества липидов в мембране за счет фосфатидилхолина Нарушение способности эритроцитов деформироваться при прохождении узких участков кровотока Внутриклеточный гемолиз эритроцитов
Наследственный стоматоцитоз Патогенез В основе два дефекта мембраны эритроцитов: 1. увеличение проницаемости для ионов натрия и калия 2. увеличение количества липидов в мембране за счет фосфатидилхолина Нарушение способности эритроцитов деформироваться при прохождении узких участков кровотока Внутриклеточный гемолиз эритроцитов
 Клинические проявления стоматоцитоза Бессимптомное течение или легкая гемолитическая анемия. Морфология эритроцитов: Эритроциты в центре имеют неокрашенный участок, ограниченный двумя изогнутыми линиями, соединенными по бокам, напоминающую форму рта.
Клинические проявления стоматоцитоза Бессимптомное течение или легкая гемолитическая анемия. Морфология эритроцитов: Эритроциты в центре имеют неокрашенный участок, ограниченный двумя изогнутыми линиями, соединенными по бокам, напоминающую форму рта.
 Врожденная абеталипопротеинемия (акантоцитоз) Клинические проявления Гемолитическая анемия Пигментный ретинит Очаговая неврологическая симптоматика Резкое снижение холестерина, фосфолипидов, триглицеридов плазмы Морфология эритроцитов За счет уменьшения содержания в мембране жирных кислот и фосфолипидов эритроциты приобретают зубчатый вид, напоминающий лист растения аканта.
Врожденная абеталипопротеинемия (акантоцитоз) Клинические проявления Гемолитическая анемия Пигментный ретинит Очаговая неврологическая симптоматика Резкое снижение холестерина, фосфолипидов, триглицеридов плазмы Морфология эритроцитов За счет уменьшения содержания в мембране жирных кислот и фосфолипидов эритроциты приобретают зубчатый вид, напоминающий лист растения аканта.
 Акантоцитоз, эхиноцитоз, пойкилозоцитоз, аницитоз (мазок крови пациента с абеталипопротеинемией)
Акантоцитоз, эхиноцитоз, пойкилозоцитоз, аницитоз (мазок крови пациента с абеталипопротеинемией)
 Лечение врожденных гемолитических анемий связанных с патологией мембраны эритроцитов Спленэктомия - высокоэффективный метод! Показания: тяжелая гемолитическая анемия частые гемолитические кризы значительная гипербилирубинемия отставание ребенка в развитии У детей операцию желательно отложить до достижения возраста 4 лет, хотя она может быть произведена в любом возрасте При малосимптомном течении лечение не проводят При проведение холецистэктомии одновременно проводят удаление селезенки
Лечение врожденных гемолитических анемий связанных с патологией мембраны эритроцитов Спленэктомия - высокоэффективный метод! Показания: тяжелая гемолитическая анемия частые гемолитические кризы значительная гипербилирубинемия отставание ребенка в развитии У детей операцию желательно отложить до достижения возраста 4 лет, хотя она может быть произведена в любом возрасте При малосимптомном течении лечение не проводят При проведение холецистэктомии одновременно проводят удаление селезенки
 Гемолитические анемии связанные с нарушением активности ферментов эритроцитов Нарушение активности ферментов гликолиза. Наиболее часто встречается дефицит активности пируваткиназы Нарушение активности ферментов пентозофосфатного цикла. Наиболее важная аномалия - дефицит активности глюкозо-6 -фосфатдегидрогеназы (самая частая наследственная аномалия из всех, встречающихся в мире) Дефицит ферментов в системе глютатиона Аномалии метаболизма нуклеотидов - дефицит активности пиримидин-5 -нуклеотидазы
Гемолитические анемии связанные с нарушением активности ферментов эритроцитов Нарушение активности ферментов гликолиза. Наиболее часто встречается дефицит активности пируваткиназы Нарушение активности ферментов пентозофосфатного цикла. Наиболее важная аномалия - дефицит активности глюкозо-6 -фосфатдегидрогеназы (самая частая наследственная аномалия из всех, встречающихся в мире) Дефицит ферментов в системе глютатиона Аномалии метаболизма нуклеотидов - дефицит активности пиримидин-5 -нуклеотидазы
 Механизмы гемолиза при дефиците ферментов гликолиза Дефицит ферментов гликолиза Нарушение выработки АТФ Изменения ионного состава эритроцитов Внутриклеточный гемолиз
Механизмы гемолиза при дефиците ферментов гликолиза Дефицит ферментов гликолиза Нарушение выработки АТФ Изменения ионного состава эритроцитов Внутриклеточный гемолиз
 Механизмы гемолиза при дефиците ферментов пентозофосфатного цикла и системы глутатиона Дефицит ферментов пентозофосфатного цикла и системы глутатиона Воздействие окислителя Окисление гемоглобина и мембраны эритроцита с образование телец Гейнца Острый внутрисосудистый гемолиз
Механизмы гемолиза при дефиците ферментов пентозофосфатного цикла и системы глутатиона Дефицит ферментов пентозофосфатного цикла и системы глутатиона Воздействие окислителя Окисление гемоглобина и мембраны эритроцита с образование телец Гейнца Острый внутрисосудистый гемолиз
 Лекарственные препараты, провоцирующие гемолиз у лиц с Г- 6 -ФДГ Противомалярийные препараты хинин, акрихин, примахин, памахин, хлорохин, дапсон Сульфаниламиды сульфапиридазин, сульфален, салазопиридазин, салазосульфапиридин Нитрофураны фурадонин, фуразолин Анальгетики фенацетин, аспирин, амидопирин, антипирин Диуретики диакарб, фонурит, тиазиды Противотуберкулезные средства изониазид, ПАСК Другие средства Левомицетин, хинидин, новарсенол, пробеницид, витамин К ( водорастворимая форма ) Конские бобы (фавизм)
Лекарственные препараты, провоцирующие гемолиз у лиц с Г- 6 -ФДГ Противомалярийные препараты хинин, акрихин, примахин, памахин, хлорохин, дапсон Сульфаниламиды сульфапиридазин, сульфален, салазопиридазин, салазосульфапиридин Нитрофураны фурадонин, фуразолин Анальгетики фенацетин, аспирин, амидопирин, антипирин Диуретики диакарб, фонурит, тиазиды Противотуберкулезные средства изониазид, ПАСК Другие средства Левомицетин, хинидин, новарсенол, пробеницид, витамин К ( водорастворимая форма ) Конские бобы (фавизм)
 Травматическое повреждение эритроцитов в кровеносном русле Прохождение эритроцитов через мелкие сосуды, расположенные над выступающими костными поверхностями, на которые оказывается давление извне Прохождение эритроцитов через градиент давления крови, образующийся при дефектах клапанов сердца; клапанных и сосудистых протезах Отложение в микроциркуляторном русле фибрина, оказывающего механическое давление на проходящие эритроциты, подвергающиеся при этом фрагментации
Травматическое повреждение эритроцитов в кровеносном русле Прохождение эритроцитов через мелкие сосуды, расположенные над выступающими костными поверхностями, на которые оказывается давление извне Прохождение эритроцитов через градиент давления крови, образующийся при дефектах клапанов сердца; клапанных и сосудистых протезах Отложение в микроциркуляторном русле фибрина, оказывающего механическое давление на проходящие эритроциты, подвергающиеся при этом фрагментации
 Этиология внутрисосудистого травматического повреждения эритроцитов Механическое давление: маршевая гемоглобинурия Пороки сердца: протезы аортального и митрального клапанов, кальцинированный стеноз аорты, заплаты на дефекте овального окна Злокачественная гипертензия Болезни сосудов: гигантская гемангиома, печеночная гемангиома, первичная легочная гипертензия Отложение фибрина в микроциркуляторном русле: ДВС, тромботическая тромбоцитопеническая пурпура, гемолитико-уремический синдром
Этиология внутрисосудистого травматического повреждения эритроцитов Механическое давление: маршевая гемоглобинурия Пороки сердца: протезы аортального и митрального клапанов, кальцинированный стеноз аорты, заплаты на дефекте овального окна Злокачественная гипертензия Болезни сосудов: гигантская гемангиома, печеночная гемангиома, первичная легочная гипертензия Отложение фибрина в микроциркуляторном русле: ДВС, тромботическая тромбоцитопеническая пурпура, гемолитико-уремический синдром
 Изоиммунные гемолитические анемии Антитела или эритроциты, содержащие антигены, против которых имеются у больного антитела, попадают в организм больного извне: Анемия новорожденных ( несовместимость по Rh или АВО между матерью и плодом) Посттрансфузионная анемия (несовместимость по Rh, АВО )
Изоиммунные гемолитические анемии Антитела или эритроциты, содержащие антигены, против которых имеются у больного антитела, попадают в организм больного извне: Анемия новорожденных ( несовместимость по Rh или АВО между матерью и плодом) Посттрансфузионная анемия (несовместимость по Rh, АВО )
 Гетероиммунные гемолитические анемии Обусловлены появлением на поверхности эритроцитов нового антигена ( гаптена ): Лекарственные Бактериальная или вирусная инфекция
Гетероиммунные гемолитические анемии Обусловлены появлением на поверхности эритроцитов нового антигена ( гаптена ): Лекарственные Бактериальная или вирусная инфекция
 Аутоиммунные гемолитические анемии Антитела вырабатываются против собственного неизмененного антигена эритроцитов: . С холодовыми антителами: холодовая гемагглютининовая болезнь и пароксизмальная холодовая гемоглобинурия С тепловыми антителами: полными или неполными Обусловленные сенсибилизацией к комплементу
Аутоиммунные гемолитические анемии Антитела вырабатываются против собственного неизмененного антигена эритроцитов: . С холодовыми антителами: холодовая гемагглютининовая болезнь и пароксизмальная холодовая гемоглобинурия С тепловыми антителами: полными или неполными Обусловленные сенсибилизацией к комплементу


